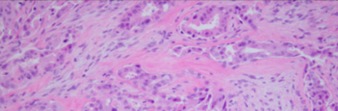
Pleomorphic Adenocarcinoma.jpg

Lacrimal Gland Tumors
All content on Eyewiki is protected by copyright law and the Terms of Service. This content may not be reproduced, copied, or put into any artificial intelligence program, including large language and generative AI models, without permission from the Academy.
Disease Entity
Lacrimal gland tumors
Disease and distribution
Lacrimal gland tumors have a yearly incidence of one in one million, representing 10% of orbital space-occupying lesions.[1][2] The age of presentation of lacrimal gland tumors depends on the specific subtype of tumor, but overall these tumors can occur at any age. Epithelial tumors, like pleomorphic adenomas and adenoid cystic carcinomas, tend to occur in patients with an average age of 40 years. Lacrimal gland lymphomas, on the other hand, usually present in patients with an average age of 70 years.[2][3][4]
These neoplasms are generally classified into two types: epithelial and non epithelial. Non epithelial lesions are the most common, corresponding to 70-80% of solid lacrimal gland masses.[1][3] The majority a secondary to non-specific inflammation (called "dacryoadenitis"). These present with acute inflammatory signs and typically respond to anti-inflammatory medicine. After these, lacrimal gland lymphomas are the most common, accounting for almost 37% of malignant lacrimal gland tumors overall.[5] The specific types of tumors within each category are outlined in the image below.[3][6][7]
Of the epithelial lacrimal gland tumors, 55% are benign while 45% are malignant.[1] The proportional difference may be even greater in Asian populations, with studies reporting up to 72-76% representing benign epithelial tumors.[8][9] The most common benign epithelial lesion in the lacrimal gland is the pleomorphic adenoma (PA, also called benign mixed tumor). Other less common benign lesions also exist, as outlined in the image below.[3][6] Of the malignant epithelial lesions, adenoid cystic carcinoma (ACC) comprises approximately 60%, with pleomorphic adenocarcinomas, primary adenocarcinomas, mucoepidermoid carcinomas, and miscellaneous tumors making up the remaining 40%.[1] This information is summarized in the images below.
Etiology
Like other neoplasms, lacrimal gland tumors are a result of abnormal cellular division. The specific cells that undergo abnormal proliferation vary based on the type of tumor. See “Histopathology” for the specific cell types involved in each tumor.
Risk factors for development of lacrimal gland tumors include age, with the highest risk being between thirty and forty years, history of lymphoma, and incomplete removal of a previous benign tumor.[10]
Genetic abnormalities have also been implicated in the development of lacrimal gland tumors. A fusion oncogene between MYB and NFIB along with a translocation between chromosome 6q22-23 and chromosome 9pq23-24 has been associated with adenoid cystic carcinoma. MYB is a transcription factor involved in the expression of cell differentiation factors, oncogenes, and housekeeping genes.[11][12] Fusion with NFIB results in significant overexpression of MYB, with subsequent abnormal cellular proliferation.[11][12]
Secondary metastasis to the lacrimal gland are quite rare but are mostly found to be associated to primary breast and lung carcinomas.[7]
Histopathology
Dacryops is a benign lacrimal duct lesion characterized by lacrimal duct epithelium cysts.[6]
Pleomorphic adenoma (PA) is pseudoencapsulated and tends to be well-defined. It is characterized by epithelial and myoepithelial elements that form lumen and spindle structures that are mixed in with other mesenchymatous structures.[13][14]
© 2019 American Academy of Ophthalmology; Images obtained from AAO: https://eyewiki.aao.org/Pleomorphic_adenoma_(benign_mixed_tumor)_of_the_lacrimal_gland
Adenoid cystic carcinoma (ACC) is characterized by solid areas or cords of bland-appearing malignant epithelial cells. The infiltrative borders of the epithelial areas can be distinguished from the surrounding connective tissue and typically show perineural invasion.[1] Immunohistochemical staining may be used to identify perineural invasion by identifying neurofilaments.[13] Adenocarcinoma and PA present myoepithelial cells in the surrounding connective tissue.[1][13] ACC can be further subdivided into histopathologic subtypes: cribriform or 'Swiss cheese', sclerosing, basaloid, comedocarcinoma, and tubular types.
© 2019 American Academy of Ophthalmology; Images obtained from AAO: https://eyewiki.aao.org/Adenoid_Cystic_Carcinoma_of_the_Lacrimal_Gland
Pleomorphic adenocarcinoma or carcinoma-ex-PA is a neoplasm resulting from the malignant transformation of a PA. It is characterized by areas of malignant change in a PA with unequal proportions of myxoid and chondroid structures, the epithelial cells also show carcinomatous changes. In comparison with PA, pleomorphic adenocarcinoma contains less gland structures and the cells show less differentiation.
© 2019 American Academy of Ophthalmology; Image obtained from AAO: Malignant Mixed Tumor of the Lacrimal Gland; Yazdanie, Fahd et al. Ophthalmology, Volume 123, Issue 8, 1736
Primary adenocarcinoma also is characterized by glandular differentiation but does not have features that identify more specific carcinoma types.
© 2019 American Academy of Ophthalmology; Image obtained from AAO: Primary Ductal Adenocarcinoma of the Lacrimal Gland; Milman, Tatyana et al. Ophthalmology, Volume 112, Issue 11, 2048 - 2051
Mucoepidermoid carcinoma contains different proportions of mucous, epidermoid, intermediate, columnar, and clear cells; a cystic component is almost always present.
Primary Squamous Cell Carcinoma (SCC) is characterized by proliferation of keratinizing malignant squamous cells that are well to moderately differentiated without any glandular structures being present.
Image not available on AAO; image available in the following publication: Hotta, K. , Arisawa, T. , Mito, H. and Narita, M. (2005), Primary squamous cell carcinoma of the lacrimal gland. Clinical & Experimental Ophthalmology, 33: 534-536. doi:10.1111/j.1442-9071.2005.01043.
Sebaceous gland carcinoma is rarely a primary lacrimal gland tumor, most cases are due to secondary involvement from the primary affectation in the eyelids. It is characterized by poorly differentiated cells with high mitoses, with positive staining for lipids contained in vacuoles in the cellular cytoplasm.
Benign lymphoepithelial lesion can undergo malignant transformation, resulting in B-cell lymphoma or lymphoepithelial carcinoma. Lymphoepithelial carcinoma is characterized by islands of undifferentiated carcinoma cells surrounded by a dense stroma made up of lymphocytes and macrophages.
Image not available on AAO; image available in the following publication: Svante R. Orell, Jerzy Klijanienko, Chapter 4 - Head and neck; salivary glands, Editor(s): Svante R Orell, Gregory F Sterrett, Orell and Sterrett's Fine Needle Aspiration Cytology (Fifth Edition), Churchill Livingstone, 2012, Pages 38-76, ISBN 9780702031519, https://doi.org/10.1016/B978-0-7020-3151-9.00004-9.
Basal cell adenocarcinoma is characterized by uniform basaloid cells without the rest of the elements found in PA. Negative Alcian blue stain and negative reaction to smooth muscle actin can help to distinguish this entity from ACC.[1]
Image not available on AAO; image available in the following publication: Mourad Khalil, Bryan Arthurs, Basal cell adenocarcinoma of the lacrimal gland, Ophthalmology, Volume 107, Issue 1, 2000, Pages 164-168, ISSN 0161-6420, https://doi.org/10.1016/S0161-6420(99)00007-X
Classification
The shared embryological origin of the salivary and lacrimal glands has led to the use of the salivary gland classification for lacrimal gland tumors. In 2006, the Armed Forces Institute of Pathology (AFIP) monograph on lacrimal gland tumors provided an expanded classification based on classification of salivary gland tumors from the World Health Organization in 1991.[15]
Diagnosis
Clinical History
The presentation of a lacrimal gland tumor depends on its size and location, but generally involves upper eyelid swelling with a mass.[16] As the size of the tumor grows, most lacrimal gland tumors will involve the following characteristics:[14][7]
- Facial asymmetry due to displacement of the globe
- Diplopia
- Ptosis
- Limited ocular motility
- Enlargement of the lacrimal gland, possibly resulting in an "S-shaped" deformity of the eyelid margin
Pleomorphic Adenomas
PAs tend to be slow growing over the course of months to years, with the development of a progressive facial asymmetry and painless proptosis.[6][17][16] The mean duration of symptoms before initial ophthalmic consultation is approximately 2 years.[1] Eventually, as the size of the tumor grows, patients may complain of the general features outlined above, including diplopia and limited ocular motility. If a patient with with long-standing symptoms of a pleomorphic adenoma suddenly experiences pain or an acceleration of symptoms, malignant transformation should be suspected.[16][18]
Lacrimal Gland Lymphomas
Lacrimal gland lymphomas tend to present in older patients, after sixty years old, but have been reported in children as well.[19] They occur bilaterally in 25% of cases and 14% present with a prior history of lymphoma. 34% present with systemic lymphoma at diagnosis. Symptoms are similar to those of other lacrimal gland tumors, including mass, diplopia, and extraocular movement restriction.[19]
Malignant Lacrimal Gland Tumors
Pain is often suggestive of malignancy and may be secondary to bone or orbital nerve involvement, particularly in patients with adenoid cystic carcinoma.[1][14] Up to 85% of ACC cases show perineural involvement, indicating more aggressive behavior.[6][20] The mean duration of symptoms before initial ophthalmic consultation is 6 months or less for patients with adenoid cystic carcinoma.[14]
Differential Diagnosis
Dacryops are lacrimal gland cysts, which typically transilluminate. When the orbital lobe is affected, the consequent proptosis and "S shaped" ptosis may make it difficult to distinguish clinically from other malignant lesions.[6] Some patients might require surgical removal for symptomatic relief or diagnostic evaluation.
Dacryoadenitis is inflammation of the lacrimal gland. This can occur as a result of viral infections, including epstein-barr virus, herpesvirus, and mumps virus.[21][22][23][24] Dacryoadenitis has also been described in association with granulomatosis with polyangiitis (formerly Wegener granulomatosis), thyroid ophthalmopathy, Sjögren's syndrome, inflammatory bowel disease, and orbital idiopathic dacryoadenitis.[25][26][27] Idiopathic cases of dacryoadenitis make up approximately thirty percent of lacrimal gland biopsies.[28]
Sjögren syndrome tends to affect both lacrimal glands with diffuse enlargement. The diagnosis includes rose Bengal staining, measurement of tear flow and biopsy of the lacrimal eye gland.[3]
Physical Examination
A complete ocular exam needs to be done including inspection and palpation of the lacrimal gland, exophthalmometry, and evaluation for ocular displacement. Hypoesthesia in the area of the first and second divisions of the trigeminal nerve are highly suggestive of perineural invasion of orbital nerves.[1]
Imaging
Computed tomography (CT) and Magnetic resonance imaging (MRI) are the most important diagnostic imaging methods. Bone changes, however, are poorly seen on MRI, making CT the better modality for bony changes and MRI for evaluation of soft tissue involvement.[29] Benign tumors (pleomorphic adenomas) tend to be well defined with moderate enhancement with IV contrast. Discrete flecks of calcification may also be seen.[16] Malignant lesions appear as poorly defined masses with infiltration into surrounding tissue. Calcifications are more common and more diffuse compared to pleomorphic adenomas.[16][30]
Management
General treatment
The management of a suspected lacrimal gland tumor depends on its imaging characteristics. Incisional biopsy should be performed in cases of bone invasion or intraorbital extension.[16] Biopsy should not be performed in cases of well-circumscribed masses. These cases should be managed as pleomorphic adenomas.[16]
Dacryops
This is a benign lesion, but symptomatic patients or patients desiring cosmetic improvement can undergo marsupialization or surgical excision with care to avoid disrupting the palpebral lobe's ducts, as this can result in inability to produce aqueous tears.[31]
Pleomorphic Adenomas
Pleomorphic adenomas make up the vast majority of benign lacrimal gland tumors.[32] The specific management approach for a pleomorphic adenoma varies based on its location but generally involves complete excision. Intraoperative capsule rupture without complete removal is associated with an increased recurrence risk.[1] Excision can be approached via an upper lid crease incision or via lateral canthal rhytids.[16]
Similar management principles apply to other benign lacrimal gland tumors as well. Diagnostic biopsies should be avoided.[17] If preoperative incisional biopsy is performed, subsequent treatment with complete surgical removal and excision of adjacent periorbital tissues may greatly reduce chance of recurrence.[3][33]
See the EyeWiki page for Pleomorphic Adenomas.
Adenoid Cystic Carcinoma
ACC management consists of tumor debulking followed by external beam radiation.[34] Although both external beam radiation and brachytherapy have been used post-operatively, brachytherapy is not as effective because it fails to prevent recurrence in the superior orbital fissure and cavernous sinus.[16] Neoadjuvant chemotherapy delivered via the external carotid artery can be helpful to reduce tumor size prior to surgical removal.[35][36]
In some patients with residual tumor after surgery, locally delivered radioactive iodine-125 plaque can be considered to avoid the need for externation.[28]
See the EyeWiki page for Adenoid Cystic Carcinoma.
Mixed Malignant Tumors (Pleomorphic Adenocarcinoma)
If the pleomorphic adenoma undergoes malignant degeneration, it is referred to as a mixed malignant tumor or pleomorphic adenocarcinoma. This is managed with local excision and irradiation.[16]
Primary Adenocarcinoma
The recommended treatment for this lesion is complete excision with adjuvant radiotherapy. Additionally, patients should have regional lymph node dissection due to the aggressive nature of this lesion.[37]
Mucoepidermoid Carcinoma
Low grade lesions are treated with excision. Radiation is given on a case by case basis. For high grade lesions, patients require externation with radiation.[38]
Primary Squamous Cell Carcinoma
This tumor is managed with local resection and radiotherapy.[39]
Sebaceous Gland Carcinoma
This neoplasm in the lacrimal gland is managed via excision with wide margins, likely via exenteration. Parotidectomy, cervical lymphadenectomy, and radiotherapy should also be considered.[40]
Benign Lymphoepithelial Lesion
These lesions are treated with a combination of glucocorticoids and surgical excision.[41]
Basal Cell Adenocarcinoma
Treatment involves surgical excision with margins of healthy tissue.[42]
Lacrimal Gland Lymphoma
Patients with localized disease are treated with radiotherapy, chemotherapy, or a combination of the two. Widespread involvement is generally treated with chemotherapy alone.[2][5]
See the EyeWiki page for Orbital Lymphomas.
Prognosis
The prognosis of a lacrimal gland tumor varies based on its classification. Below is prognostic information for the different subtypes of lacrimal gland tumors discussed on this page:
Dacryops
This is a benign condition, but incomplete resection can result in recurrence.[31]
Pleomorphic Adenoma
The prognosis of PA is generally good, but this type of tumor has the potential to recur locally. While it is a benign neoplasm, it has the potential for malignant transformation. Multiple recurrences increase the risk of malignant transformation, especially in patients older than 45 years.[14]
Adenoid Cystic Carcinoma
Lacrimal gland carcinomas are often aggressive, with an average survival of only 36 months. After the initial lesion is treated, the 10-year survival of ACC is approximately 20-30%.[14] Distant metastasis occurs in 50% of patients with ACC.[1] Local recurrence is more likely in cases with perineural invasion, microscopically positive resection margin, and a larger tumor size.[20] A solid growth pattern or basaloid differentiation is associated with more aggressive tumors and a reduction in disease-free survival.[17]
Pleomorphic Adenocarcinoma
This malignant lesion is usually well demarcated, but intracranial invasion and spinal metastasis are possible.[43]
Primary Adenocarcinoma
This is a very aggressive tumor with poor prognosis. Due to the rare nature of this neoplasm, strong prognostic data is lacking, but estimates suggest a death rate of 70% within three years.[37]
Mucoepidermoid Carcinoma
These tumors have poor prognosis with metastasis to the brain, lung, and mediastinum.[38]
Primary Squamous Cell Carcinoma
There is insufficient data for prognostic estimates of this tumor. Case reports have reported survival of more than fifteen years.[39]
Sebaceous Gland Carcinoma
This is a rare neoplasm, and prognostic data is scarce. Case reports suggest aggressive behavior, with early metastasis to preauricular and cervical lymph nodes.[40]
Basal Cell Adenocarcinoma
This is a relatively low grade malignancy, but metastasis to the lymph nodes and lungs is possible. This rare malignancy lacks sufficient prognostic data, but case reports show survival of over ten years.[42]
References
- ↑ 1.00 1.01 1.02 1.03 1.04 1.05 1.06 1.07 1.08 1.09 1.10 1.11 Shields JA, Shields CL, Epstein J, et al. Primary epithelial malignancies of the lacrimal gland. The 2003 Ramon L. Font Lecture. Ophthalmic Plast Reconstr Surg 2004;20:10–21
- ↑ 2.0 2.1 2.2 von Holstein SL, Therkildsen MH, Prause JU, et al. Lacrimal gland lesions in Denmark between 1974 and 2007. Acta Ophthalmol. 2013;91:349-354
- ↑ 3.0 3.1 3.2 3.3 3.4 3.5 Gao Y, Moonis G, Cunnane ME, Eisenberg RL. Lacrimal gland masses. AJR Am J Roentgenol 2013 Sep;201(3):W371-81
- ↑ Shields JA, Shields CL, Scartozzi R. Survey of 1264 patients with orbital tumors and simulating lesions: The 2002 Montgomery Lecture, part 1. Ophthalmology 2004;111:997–1008.
- ↑ 5.0 5.1 Rasmussen P, Ralfkiaer E, Prause JU, Sjö LD, Siersma VD, Heegaard S. Malignant Lymphoma of the Lacrimal Gland: A Nation-Based Study. Arch Ophthalmol. 2011;129(10):1275–1280. doi:10.1001/archophthalmol.2011.270
- ↑ 6.0 6.1 6.2 6.3 6.4 6.5 Bernardini FP, Devoto MH, Croxatto JO. Epithelial tumors of the lacrimal gland: an update. Curr Opin Ophthalmol 2008;19:409–13
- ↑ 7.0 7.1 7.2 Santos RR, Damasceno RW, de Pontes FS, Cursino SR, Nishiwaki-Dantas MC, Vital Filho J, Dantas PE. Ten-year follow-up of a case series of primary epithelial neoplasms of the lacrimal gland: clinical features, surgical treatment and histopathological findings. Arq Bras Oftalmol. 2010 Jan-Feb;73(1):33-9
- ↑ Chawla B, Kashyap S, Sen S, Bajaj MS, Pushker N, Gupta K, Chandra M, Ghose S. Clinicopathologic review of epithelial tumors of the lacrimal gland. Ophthal Plast Reconstr Surg 2013 Nov-Dec;29(6):440-5
- ↑ Zeng J, Shi JT, Li B, et al. Epithelial tumors of the lacrimal gland in the Chinese: a clinicopathologic study of 298 patients. Graefes Arch Clin Exp Ophthalmol 2010;248:1345–9
- ↑ (2015, September 23). Lacrimal Gland Tumor. Retrieved from https://www.cancer.net/cancer-types/lacrimal-gland-tumor
- ↑ 11.0 11.1 Persson M, Andren Y, Mark J, Horlings HM, Persson F, Stenman G. Recurrent fusion of MYB and NFIB transcription factor genes in carcinomas of the breast and head and neck. Proc Natl Acad Sci. 2009;106:18740–4.
- ↑ 12.0 12.1 Mikse, O. R., Tchaicha, J. H., Akbay, E. A., Chen, L., Bronson, R. T., Hammerman, P. S., & Wong, K. K. (2016). The impact of the MYB-NFIB fusion proto-oncogene in vivo. Oncotarget, 7(22), 31681–31688. doi:10.18632/oncotarget.9426
- ↑ 13.0 13.1 13.2 Mendoza PR, Jakobiec FA, Krane JF. Immunohistochemical features of lacrimal gland epithelial tumors. Am J Ophthalmol 2013 Dec;156(6):1147-1158
- ↑ 14.0 14.1 14.2 14.3 14.4 14.5 von Holstein SL, Rasmussen PK, Heegaard S. Tumors of the Lacrimal Gland. Semin Diagn Pathol. 2016 May;33(3):156-63
- ↑ Weis E, Rootman J, Joly TJ, Berean KW, Al-Katan HM, Pasternak S, Bonavolontà G, Strianese D, Saeed P, Feldman KA, Vangveeravong S, Lapointe JS, White VA. Epithelial lacrimal gland tumors: pathologic classification and current understanding. Arch Ophthalmol. 2009 Aug;127(8):1016-28
- ↑ 16.0 16.1 16.2 16.3 16.4 16.5 16.6 16.7 16.8 16.9 26 Verity D.H., Durrani O.M., Rose G.E. (2014) Lacrimal Gland Tumors. In: Perry J., Singh A. (eds) Clinical Ophthalmic Oncology. Springer, Berlin, Heidelberg
- ↑ 17.0 17.1 17.2 Perez DE, Pires FR, Almeida OP, Kowalski LP. Epithelial lacrimal gland tumors: a clinicopathological study of 18 cases. Otolaryngol Head Neck Surg. 2006 Feb;134(2):321-5
- ↑ Perzin KH, Jakobiec FA, Livolsi VA, Desjardins L. Lacrimal gland malignant mixed tumors (carcinomas arising in benign mixed tumors): a clinico-pathologic study. Cancer. 1980;45:2593–606.
- ↑ 19.0 19.1 Jenkins, C., et al. (2003). "Clinical features associated with survival of patients with lymphoma of the ocular adnexa." Eye (Lond) 17(7): 809-820.
- ↑ 20.0 20.1 Woo KI, Yeom A, Esmaeli B. Management of Lacrimal Gland Carcinoma: Lessons From the Literature in the Past 40 Years. Ophthal Plast Reconstr Surg 2016 Jan-Feb;32(1):1-10.
- ↑ Rhem MN, Wilhelmus KR, Jones DB. Epstein-barr virus dacryoadenitis. Am J Ophthalmol 2000;129:372-5.
- ↑ Foster WJ Jr, Kraus MD, Custer PL. Herpes simplex virus dacryoadenitis in an immunocompromised patient. Arch Ophthalmol 2003;121:911-3.
- ↑ Obata H, Yamagami S, Saito S, et al. A case of acute dacryoadenitis associated with herpes zoster ophthalmicus. Jpn J Ophthalmol 2003;47:107-9.
- ↑ Galpine JF, Walkowski J. A case of mumps with involvement of the lacrimal glands. Br Med J 1952;1(4767):1069-70.
- ↑ Kiratli H, Sekeroglu MA, Soylemezoglu F. Unilateral dacryoadenitis as the sole presenting sign of Wegener's granulomatosis. Orbit 2008;27(3):157-60.
- ↑ Dutt S, Cartwright MJ, Nelson CC. Acute dacryoadenitis and crohn's disease: Findings and management. Ophthal Plast Reconstr Surg 1992;8(4):295-9.
- ↑ Witmer, M. (2009, August 13). Unraveling the Difficult Diagnosis of Dacryoadenitis. Retrieved from https://www.reviewofophthalmology.com/article/unraveling-the-difficult-diagnosis-of-dacryoadenitis
- ↑ 28.0 28.1 Shields JA, Shields CL, Freire JE, Brady LW, Komarnicky L. Plaque radiotherapy for selected orbital malignancies: preliminary observations: the 2002 Montgomery Lecture, part 2. Ophthal Plast Reconstr Surg 2003 Mar;19(2):91-5
- ↑ Aviv RI, Miszkiel K. Orbital imaging: part 2. Intraorbital pathology. Clin Radiol. 2005;60:288–307.
- ↑ Wright JE, Rose GE, Garner A. Primary malignant neoplasms of the lacrimal gland. Br J Ophthalmol. 1992;76:401–7.
- ↑ 31.0 31.1 (2019, May 4). Dacryops. Retrieved from https://eyewiki.aao.org/Dacryops
- ↑ Rose GE, Wright JE. Pleomorphic adenoma of the lacrimal gland. Br J Ophthalmol. 1992;76:395–400.
- ↑ Alkatan HM, Al-Harkan DH, Al-Mutlaq M, Maktabi A, Elkhamary SM. Epithelial lacrimal gland tumors: A comprehensive clinicopathologic review of 26 lesions with radiologic correlation. Saudi J Ophthalmol 2014 Jan;28(1):49-57
- ↑ Wright JE, Rose GE, Garner A. Primary malignant neoplasms of the lacrimal gland. Br J Ophthalmol. 1992;76:401–7.
- ↑ Meldrum ML, Tse DT, Benedetto P. Neoadjuvant intracarotid chemotherapy for treatment of advanced adenocystic carcinoma of the lacrimal gland. Arch Ophthalmol. 1998;116:315–21.
- ↑ Tse DT, Benedetto P, Dubovy S, Schiffman JC, Feuer WJ. Clinical analysis of the effect of intraarterial cytoreductive chemotherapy in the treatment of lacrimal gland adenoid cystic carcinoma. Am J Ophthalmol. 2006;141:44–53.
- ↑ 37.0 37.1 Touil A, El Abbassi S, Echchikhi Y, Maher M, Kebdani T, Benjaafar N. Adenocarcinoma of the lacrimal gland: a case report. J Med Case Rep. 2017;11(1):257. Published 2017 Sep 11. doi:10.1186/s13256-017-1412-2
- ↑ 38.0 38.1 Hwang SJ, Kim KH. High-grade Mucoepidermoid Carcinoma of the Lacrimal Gland. Korean J Ophthalmol. 2018;32(5):426–427. doi:10.3341/kjo.2018.0026
- ↑ 39.0 39.1 Hotta, K. , Arisawa, T. , Mito, H. and Narita, M. (2005), Primary squamous cell carcinoma of the lacrimal gland. Clinical & Experimental Ophthalmology, 33: 534-536. doi:10.1111/j.1442-9071.2005.01043.x
- ↑ 40.0 40.1 BRISCOE D, MAHMOOD S, BONSHEK R, et al. Primary sebaceous carcinoma of the lacrimal glandBritish Journal of Ophthalmology 2001;85:625.
- ↑ Svante R. Orell, Jerzy Klijanienko, Chapter 4 - Head and neck; salivary glands, Editor(s): Svante R Orell, Gregory F Sterrett, Orell and Sterrett's Fine Needle Aspiration Cytology (Fifth Edition), Churchill Livingstone, 2012, Pages 38-76, ISBN 9780702031519, https://doi.org/10.1016/B978-0-7020-3151-9.00004-9.
- ↑ 42.0 42.1 Mourad Khalil, Bryan Arthurs, Basal cell adenocarcinoma of the lacrimal gland, Ophthalmology, Volume 107, Issue 1, 2000, Pages 164-168, ISSN 0161-6420, https://doi.org/10.1016/S0161-6420(99)00007-X.
- ↑ Ahn JY, Chang JH, Kim SH, Lee KS. Pleomorphic adenocarcinoma of the lacrimal gland with multiple intracranial and spinal metastases. World J Surg Oncol. 2007;5:29. Published 2007 Mar 7. doi:10.1186/1477-7819-5-29
- Hassan WM, Bakry MS, Hassan HM, Alfaar AS. Incidence of orbital, conjunctival and lacrimal gland malignant tumors in USA from Surveillance, Epidemiology and End
- Shields JA, Shields CL. Lacrimal gland primary epithelial tumors. In: Shields JA, Shields CL, eds. Eyelid, Orbital and Conjunctival Tumors, An Atlas and Textbook. 2nd ed. Philadelphia, PA: Lippincott, Williams and Wilkins, 2008:700–25
- Le Tourneau C, Razak AR, Levy C, Calugaru V, Galatoire O, Dendale R, Desjardins L & Gan HK. Role of chemotherapy and molecularly targeted agents in the treatment of adenoid cystic carcinoma of the lacrimal gland. Br J Ophthalmol 2011;95: 1483–1489.
- von Holstein SL. Tumours of the lacrimal gland. Epidemiological, clinical and genetic characteristics. Acta Ophthalmol 2013 Nov;91 Thesis 6:1-28
- Huang SK, Tsai CC, Lin CH, Kau HC, Kao SC, Lee FL. Lacrimal gland pleomorphic adenoma masquerading as thyroid-associated ophthalmopathy.Am J Med Sci. 2013 Aug;346(2):162-3. doi: 10.1097
- Noh JM, Lee E, Ahn YC, Oh D, Kim YD, Woo KI, Ko YH, Kim S. Clinical significance of post-surgical residual tumor burden and radiation therapy in treating patients with lacrimal adenoid cystic carcinoma.Oncotarget. 2016 Sep 13;7(37):60639-60646
- Tse DT, Kossler AL, Feuer WJ, Benedetto PW. Long-term outcomes of neoadjuvant intra-arterial cytoreductive chemotherapy for lacrimal gland adenoid cystic carcinoma. Ophthalmology 2013 Jul;120(7):1313-23
- Woo KI1, Kim YD, Sa HS, Esmaeli B. Current treatment of lacrimal gland carcinoma. Curr Opin Ophthalmol. 2016 Sep;27(5):449-56.
- Sant DW, Tao W, Field MG, Pelaez D, Jin K, Capobianco A, Dubovy SR, Tse DT, Wang G. Whole Exome Sequencing of Lacrimal Gland Adenoid Cystic Carcinoma.Invest Ophthalmol Vis Sci. 2017 May 1;58(6)
- von Holstein SL, Coupland SE, Briscoe D, Le Tourneau C, Heegaard S. Epithelial tumours of the lacrimal gland: a clinical, histopathological, surgical and oncological survey. Acta Ophthalmol 2013 May;91(3):195-206
- Heaps RS, Miller NR, Albert DM, et al. Primary adenocarcinoma of the lacrimal gland. A retrospective study. Ophthalmology. 1993;100:1856–60.
- Tse D. Clinical and microdissection genotyping analyses of the effect of intra-arterial cytoreductive chemotherapy in the treatment of lacrimal gland adenoid cystic carcinoma. Trans Am Ophthalmol Soc. 2005;103:337–67.
- Nicholas H. Andrew, Daniel Kearney, Nicole Sladden, Penny McKelvie, Albert Wu, Michelle T. Sun, Alan McNab, Dinesh Selva,
- Idiopathic Dacryoadenitis: Clinical Features, Histopathology, and Treatment Outcomes, American Journal of Ophthalmology, Volume 163, 2016, Pages 148-153.e1, ISSN 0002-9394, https://doi.org/10.1016/j.ajo.2015.11.032. (http://www.sciencedirect.com/science/article/pii/S0002939415300076)